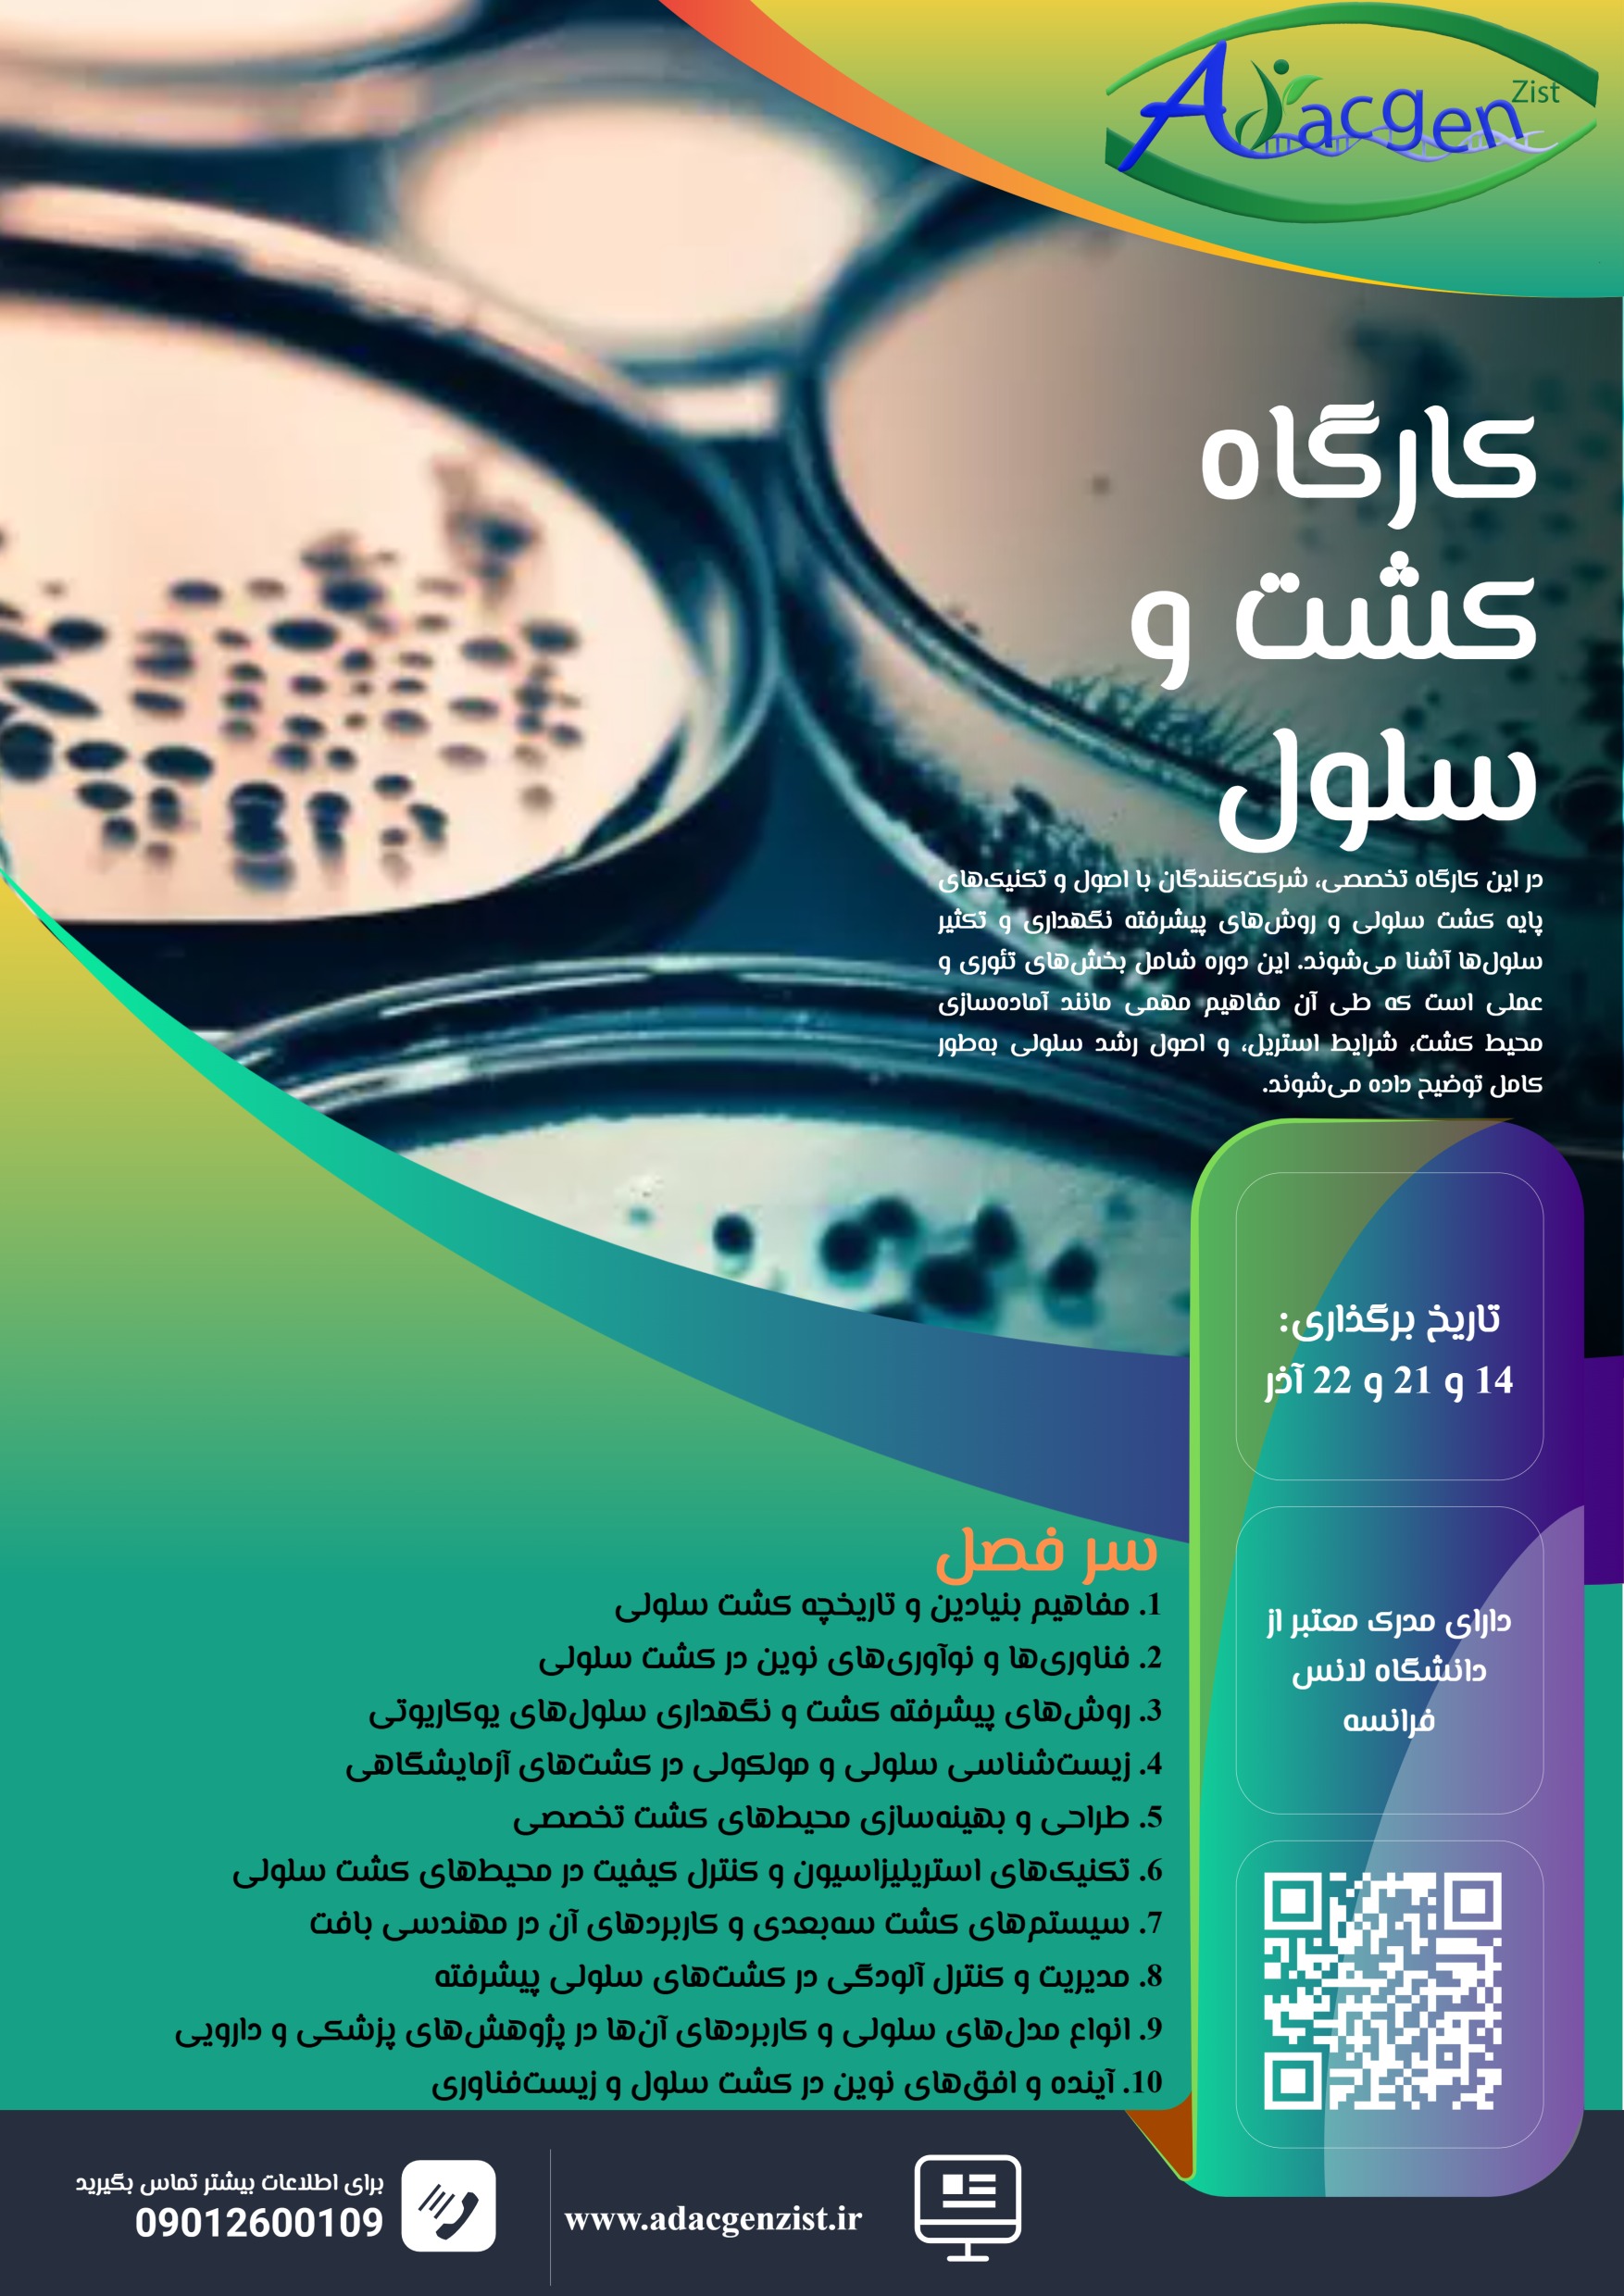
کارگاه کشت سلولی

توضیحات
⚠️کارگاه تخصصی کشت و سلول ⚠️
برای اولین بار در کشور!
آموزش تخصصی همراه با ارائه مدرک بینالمللی از دانشگاه Artois فرانسه
اساتید دوره:
دکتر اکرمی
دکتر ملائی
✨ تخفیف ویژه این دوره:
این کارگاه برای اولین بار برگزار میشود و به همین دلیل هزینه شرکت در آن با تخفیف استثنایی از 5,000,000 تومان به 3,000,000 تومان کاهش یافته است!
زمان برگزاری:
14 و 21 آذر: ساعت 9:00 الی 13:00
22 آذر: ساعت 9:00 الی 18:00
⚠️ویژگیهای دوره:
✔️ تدریس اصول و تکنیکهای پیشرفته توسط اساتید برجسته
✔️ مناسب برای دانشجویان، محققان و علاقهمندان زیستشناسی سلولی
✔️ ارائه مدرک معتبر بینالمللی قابل استعلام
سرفصلهای کارگاه:
1. مفاهیم بنیادین و تاریخچه کشت سلولی
2. فناوریها و نوآوریهای نوین در کشت سلولی
3. روشهای پیشرفته کشت و نگهداری سلولهای یوکاریوتی
4. زیستشناسی سلولی و مولکولی در کشتهای آزمایشگاهی
5. آشنایی با تجهیزات تخصصی
6. تکنیکهای استریلیزاسیون و کنترل کیفیت در محیطهای کشت سلولی
7. سیستمهای کشت سهبعدی و کاربردهای آن در مهندسی بافت
8. روشهای بررسی آلودگی در کشتهای سلولی پیشرفته
9. آشنایی با خطوط سلولی و کاربردهای آنها در پژوهشهای پزشکی و دارویی
10. آینده نوآوریهای مرتبط با کشت سلولی و زیستفناوری
هزینه ثبتنام: فقط 3,000,000 تومان (تخفیف ویژه)
ثبتنام از طریق وبسایت: adacgenzist.ir
کانال تلگرامی: t.me/Adacgenzist
پشتیبانی ثبتنام:
@Adacgen_supporters

نقد و بررسیها
هنوز بررسیای ثبت نشده است.